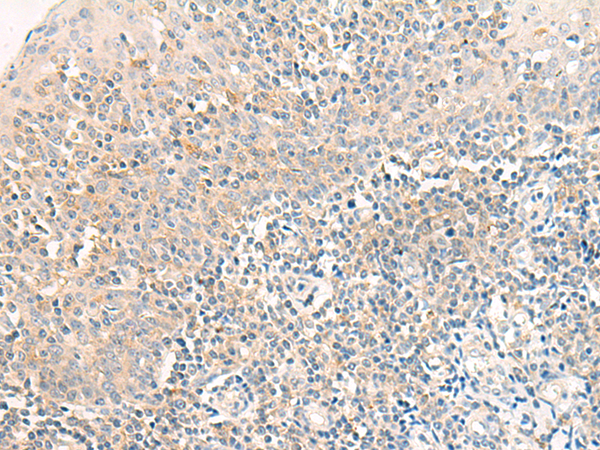
一抗

中文名稱: 兔抗RAPGEF1多克隆抗體
英文名稱: Anti-RAPGEF1 rabbit polyclonal antibody
別 名: Rap guanine nucleotide exchange factor 1; C3G; GRF2
抗 原: RAPGEF1
儲 存: 冷凍(-20℃)
宿 主: Rabbit
反應(yīng)種屬: Human
相關(guān)類別: 一抗
標(biāo) 記 物: Unconjugate
克隆類型: rabbit polyclonal
技術(shù)規(guī)格
|
Background: |
This gene encodes a human guanine nucleotide exchange factor. It transduces signals from CRK by binding the SH3 domain of CRK, and activating several members of the Ras family of GTPases. This signaling cascade that may be involved in apoptosis, integrin-mediated signal transduction, and cell transformation. Several alternatively spliced transcript variants of this gene have been described, but the full-length nature of some variants has not been determined. |
|
Applications: |
ELISA, IHC |
|
Name of antibody: |
RAPGEF1 |
|
Immunogen: |
Synthetic peptide of human RAPGEF1 |
|
Full name: |
Rap guanine nucleotide exchange factor 1 |
|
Synonyms: |
C3G; GRF2 |
|
SwissProt: |
Q13905 |
|
ELISA Recommended dilution: |
5000-10000 |
|
IHC positive control: |
Human tonsil |
|
IHC Recommend dilution: |
25-100 |

 購物車
購物車 幫助
幫助
 021-54845833/15800441009
021-54845833/15800441009